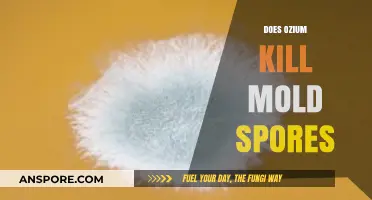
Does Ozium Effectively Kill Mold Spores? A Comprehensive Analysis

Ozone, a powerful oxidizing agent, has been widely studied for its antimicrobial properties, particularly its efficacy against various pathogens, including bacteria. One area of interest is its ability to kill bacterial spores, which are highly resistant forms of bacteria capable of surviving harsh environmental conditions. Bacterial spores, such as those produced by *Clostridium difficile* and *Bacillus* species, pose significant challenges in healthcare and food safety due to their resilience. Research indicates that ozone can effectively inactivate bacterial spores through mechanisms involving the oxidation of spore coat proteins, DNA, and other essential cellular components. However, the effectiveness of ozone depends on factors like concentration, exposure time, and environmental conditions. Understanding ozone's role in spore inactivation is crucial for developing disinfection strategies in medical, industrial, and environmental settings.
| Characteristics | Values |
|---|---|
| Effectiveness on Bacterial Spores | Ozone is effective in killing bacterial spores, but requires higher concentrations and longer exposure times compared to vegetative bacteria. |
| Mechanism of Action | Ozone oxidizes cell walls, disrupts DNA, and damages proteins in spores, leading to cell death. |
| Required Concentration | Typically requires concentrations of 1-10 ppm (parts per million) for effective spore inactivation. |
| Exposure Time | Longer exposure times (e.g., 30 minutes to several hours) are needed for complete spore eradication. |
| Temperature Dependence | Higher temperatures (e.g., 20-40°C) enhance ozone's efficacy against spores. |
| Humidity Influence | Higher humidity levels can improve ozone's penetration and effectiveness against spores. |
| Applications | Used in water treatment, food processing, and medical device sterilization for spore inactivation. |
| Limitations | Less effective in organic-rich environments due to ozone scavenging by organic matter. |
| Safety Considerations | High ozone concentrations are toxic to humans and require controlled environments for application. |
| Resistance | Some bacterial spores (e.g., Clostridium difficile) may require even higher ozone doses or additional treatments. |
Explore related products
$28.99
What You'll Learn
- Ozone's effectiveness against bacterial spores in water treatment processes
- Mechanisms of ozone inactivating bacterial spores on surfaces
- Role of ozone concentration in spore destruction efficiency
- Comparison of ozone and other disinfectants on bacterial spores
- Impact of exposure time on ozone's spore-killing capability

Ozone's effectiveness against bacterial spores in water treatment processes
Ozone's potent oxidizing properties make it a formidable agent in water treatment, particularly against bacterial spores, which are notoriously resistant to disinfection. Unlike vegetative bacteria, spores possess a robust outer coating that shields their genetic material, enabling them to withstand harsh environmental conditions. However, ozone’s unique mechanism of action—oxidizing cell walls and disrupting cellular functions—positions it as a critical tool in eliminating these resilient organisms from water supplies.
To effectively target bacterial spores in water treatment, precise ozone dosing is essential. Studies indicate that ozone concentrations of 1–4 mg/L, applied for 10–30 minutes, can achieve significant spore inactivation. For instance, *Bacillus subtilis* spores, a common surrogate for spore-forming pathogens, are effectively reduced by 99.9% under these conditions. However, factors such as water pH, temperature, and organic matter content can influence ozone’s efficacy. Lower pH levels (below 7) enhance ozone’s oxidizing power, while higher temperatures accelerate reaction rates. Operators must monitor these parameters to optimize treatment outcomes.
A comparative analysis reveals ozone’s advantages over traditional disinfectants like chlorine. While chlorine is effective against vegetative bacteria, it struggles to penetrate spore coatings, often requiring prolonged contact times or high doses. Ozone, in contrast, acts rapidly and decomposes into oxygen, leaving no harmful byproducts. This makes it particularly suitable for applications where chemical residue is a concern, such as drinking water treatment. However, ozone’s instability necessitates on-site generation, adding complexity to treatment systems.
Practical implementation of ozone in water treatment requires careful planning. Systems should incorporate pre-treatment steps, such as filtration, to reduce organic load and enhance ozone efficiency. Post-ozonation, residual spores can be further controlled through secondary disinfection methods, such as UV light or chlorination. Regular monitoring of spore counts and ozone residuals ensures compliance with regulatory standards, such as the EPA’s guidelines for drinking water. For small-scale applications, portable ozone generators offer a cost-effective solution, though they require precise calibration to avoid under- or over-treatment.
In conclusion, ozone’s effectiveness against bacterial spores in water treatment is well-documented, but its success hinges on meticulous application. By tailoring dosage, considering environmental factors, and integrating complementary technologies, water treatment facilities can harness ozone’s power to deliver safe, spore-free water. As research advances, ozone’s role in addressing emerging contaminants and enhancing water security is poised to expand, solidifying its position as a cornerstone of modern water treatment.
Understanding Clostridium Botulinum: Sporulation Process and Formation Explained
You may want to see also

Mechanisms of ozone inactivating bacterial spores on surfaces
Ozone's ability to inactivate bacterial spores on surfaces hinges on its potent oxidizing power, which disrupts critical spore structures. Unlike vegetative bacteria, spores possess a robust outer coat and a dehydrated, metabolically dormant core, making them highly resistant to environmental stressors. Ozone, however, can penetrate this protective barrier through several mechanisms. First, it directly oxidizes proteins and lipids in the spore coat, compromising its integrity. Second, ozone reacts with the spore's DNA, causing strand breaks and cross-linking that prevent replication. Third, it disrupts the germ cell wall by oxidizing peptidoglycan, a key structural component. These combined actions render the spore unable to germinate or resume metabolic activity, effectively inactivating it.
To maximize ozone's efficacy against bacterial spores, specific conditions must be met. Ozone concentration and exposure time are critical factors. Studies show that ozone concentrations of 20–50 ppm (parts per million) for 30–60 minutes are effective against *Bacillus subtilis* spores, a common surrogate for *Bacillus anthracis*. Humidity levels also play a role; higher humidity (70–85%) enhances ozone's reactivity by facilitating the formation of hydroxyl radicals, which are even more reactive than ozone itself. Surface material matters too—porous surfaces may require longer exposure times due to ozone's limited penetration. For practical applications, such as in healthcare or food processing, combining ozone treatment with mechanical action (e.g., wiping or brushing) can improve spore inactivation by removing debris that might shield spores.
A comparative analysis reveals ozone's advantages over traditional disinfectants like chlorine or hydrogen peroxide. Unlike chlorine, ozone leaves no harmful residues, making it safer for food contact surfaces. It also acts faster than hydrogen peroxide, particularly at higher concentrations. However, ozone's instability requires on-site generation, and its effectiveness diminishes in the presence of organic matter. This highlights the need for pre-cleaning surfaces before ozone treatment. For example, in a hospital setting, surfaces should be wiped with a detergent solution to remove organic load before ozone exposure. This two-step approach ensures optimal spore inactivation while minimizing ozone's limitations.
From a practical standpoint, implementing ozone for spore inactivation requires careful planning. Portable ozone generators are ideal for targeted applications, such as disinfecting laboratory equipment or small rooms. For larger areas, centralized ozone systems with precise control over concentration and exposure time are more efficient. Safety is paramount; ozone is toxic at high concentrations, so treatment should occur in unoccupied spaces with proper ventilation. Post-treatment, allow residual ozone to dissipate (typically 1–2 hours) before re-entry. Regular monitoring with ozone sensors ensures compliance with occupational exposure limits (0.1 ppm for 8 hours). By adhering to these guidelines, ozone can be a powerful tool for eliminating bacterial spores on surfaces in various industries.
Spore-Forming Bacteria: Gram-Positive or Gram-Negative Classification Explained
You may want to see also

Role of ozone concentration in spore destruction efficiency
Ozone's effectiveness in destroying bacterial spores hinges critically on its concentration. At low levels (below 0.1 ppm), ozone exhibits minimal sporicidal activity, often insufficient for practical applications. This is because bacterial spores possess robust, multi-layered structures that resist penetration by weak oxidizing agents. For instance, *Clostridium difficile* spores, notorious for their resilience, remain largely unaffected by ambient ozone levels found in typical indoor environments.
To achieve meaningful spore destruction, ozone concentrations must reach significantly higher thresholds. Research indicates that levels between 1–5 ppm can effectively inactivate spores within 30–60 minutes, depending on the species. For example, *Bacillus subtilis* spores, commonly used as surrogates in laboratory studies, are inactivated at 2 ppm ozone exposure for 45 minutes. However, achieving such concentrations requires specialized equipment and controlled environments, as these levels far exceed safe human exposure limits (0.1 ppm for short-term exposure).
Practical applications of ozone for spore destruction demand precise control over concentration and exposure time. In water treatment systems, ozone is often applied at 2–4 ppm for 15–30 minutes to ensure spore inactivation, particularly in healthcare settings where *C. difficile* contamination is a concern. Similarly, in food processing, ozone at 3–5 ppm is used to decontaminate surfaces and equipment, though exposure times must be strictly monitored to avoid material degradation.
A comparative analysis reveals that while ozone is potent, its efficacy is not universal. Spores of *Geobacillus stearothermophilus*, for instance, require higher concentrations (up to 6 ppm) and longer exposure times (90 minutes) due to their thicker exosporium layers. This variability underscores the need for species-specific protocols when employing ozone for spore destruction.
In conclusion, ozone concentration is a decisive factor in spore destruction efficiency. While low concentrations are ineffective, higher levels (1–6 ppm) can reliably inactivate spores, provided exposure times are optimized. Practical implementation requires careful calibration, adherence to safety standards, and consideration of spore species. For those seeking to harness ozone's sporicidal potential, precision in concentration and exposure is non-negotiable.
Are Spores Legal in Jordan? Understanding Local Laws and Regulations
You may want to see also
Explore related products

Comparison of ozone and other disinfectants on bacterial spores
Ozone's efficacy against bacterial spores is a critical consideration in disinfection strategies, particularly in healthcare and food processing industries where spore-forming bacteria like *Clostridium difficile* and *Bacillus anthracis* pose significant risks. Unlike many chemical disinfectants, ozone is a gas that can penetrate hard-to-reach surfaces and does not leave behind residues, making it an attractive option. However, its effectiveness against bacterial spores is highly dependent on concentration and exposure time. Studies show that ozone at concentrations of 2–5 ppm for 30–60 minutes can inactivate bacterial spores, though this requires controlled environments to ensure safety and efficacy.
In comparison, chlorine-based disinfectants, such as sodium hypochlorite, are widely used due to their broad-spectrum activity and low cost. Chlorine at concentrations of 5,000–10,000 ppm can effectively kill bacterial spores within 10–30 minutes, but it leaves residues and can corrode surfaces over time. Additionally, chlorine’s effectiveness diminishes in the presence of organic matter, a limitation ozone does not share. However, chlorine’s proven track record and ease of use make it a staple in many disinfection protocols, despite its drawbacks.
Hydrogen peroxide vapor (HPV) is another potent disinfectant often compared to ozone, particularly in healthcare settings. HPV at 35% concentration can achieve sporicidal activity within 30–60 minutes, depending on the spore type and environmental conditions. Unlike ozone, HPV does not require high humidity for activation, making it more versatile. However, HPV systems are expensive and require specialized equipment, whereas ozone generators are more accessible and cost-effective for smaller-scale applications.
A key advantage of ozone is its environmental friendliness; it decomposes into oxygen, leaving no harmful byproducts. In contrast, chemical disinfectants like formaldehyde and glutaraldehyde, though effective against spores, are toxic and require careful handling. For instance, formaldehyde gas at 8–12 g/m³ for 12–24 hours can sterilize environments but poses significant health risks, making it unsuitable for routine use. Ozone, while safer in this regard, requires strict adherence to safety guidelines to prevent respiratory irritation at concentrations above 0.1 ppm.
Practical considerations further differentiate ozone from other disinfectants. For example, in water treatment, ozone at 0.4–0.8 ppm can inactivate bacterial spores within minutes, outperforming UV treatment, which is ineffective against spores. However, ozone’s instability requires on-site generation, whereas UV systems are simpler to maintain. In food processing, ozone’s ability to degrade pesticides and extend shelf life makes it superior to chemical sanitizers, which can alter food quality. Ultimately, the choice between ozone and other disinfectants hinges on specific application needs, balancing efficacy, cost, and safety.
Understanding the Meaning of 'Spor' in Ancient Roman Culture and Language
You may want to see also

Impact of exposure time on ozone's spore-killing capability
Ozone's effectiveness in killing bacterial spores is heavily influenced by exposure time, a critical factor that determines its success in disinfection processes. Studies show that ozone can indeed inactivate bacterial spores, but the required exposure duration varies significantly depending on the spore type, ozone concentration, and environmental conditions. For instance, *Clostridium sporogenes* spores, commonly used as surrogates for *Bacillus anthracis*, require exposure to 200 ppm of ozone for at least 4 hours to achieve a 6-log reduction, while *Bacillus subtilis* spores may need even longer durations. This variability underscores the importance of tailoring exposure times to specific spore characteristics.
To maximize ozone's spore-killing capability, it is essential to follow a structured approach. Begin by identifying the target spore species and its known resistance to ozone. Next, determine the appropriate ozone concentration, typically ranging from 50 to 500 ppm, based on the application. For example, water treatment systems often use lower concentrations (50–100 ppm) but extend exposure times to 2–4 hours, while air disinfection in controlled environments may employ higher concentrations (200–500 ppm) for shorter durations (30–60 minutes). Always monitor ozone levels using calibrated sensors to ensure consistency and safety.
A comparative analysis reveals that longer exposure times generally enhance ozone's efficacy, but practical limitations often dictate a balance between time and concentration. For instance, in food processing, where ozone is used to decontaminate surfaces, a 100 ppm treatment for 1 hour may suffice for less resistant spores, while more resilient spores might require 200 ppm for 2 hours. However, prolonged exposure to high ozone concentrations can degrade materials like rubber and plastics, necessitating careful consideration of the treatment environment. This trade-off highlights the need for optimized protocols that minimize damage while ensuring spore inactivation.
From a persuasive standpoint, investing in precise control of exposure time is a game-changer for industries relying on ozone disinfection. For example, healthcare facilities can significantly reduce the risk of spore-related infections by implementing 30-minute ozone treatments at 250 ppm in patient rooms, a protocol supported by studies demonstrating 99.99% spore inactivation. Similarly, agricultural operations can safeguard produce by applying 150 ppm ozone for 1 hour during post-harvest processing. By prioritizing exposure time optimization, organizations can achieve both regulatory compliance and operational efficiency, making ozone a reliable tool in the fight against bacterial spores.
Pine Cones and Spores: Unraveling the Mystery of Their Reproduction
You may want to see also
Frequently asked questions
Yes, ozone is highly effective at killing bacterial spores due to its strong oxidizing properties, which disrupt the spore's cell wall and DNA.
Ozone is more effective than many chemical disinfectants in killing bacterial spores because it penetrates cell walls and reacts rapidly with cellular components, leaving no harmful residues.
The concentration required varies, but typically, ozone levels between 1-10 ppm (parts per million) over an extended exposure time (e.g., 30 minutes to several hours) are effective against bacterial spores.
Ozone is effective in various environments, including air, water, and surfaces, but it requires proper ventilation and controlled conditions, as high concentrations can be harmful to humans and animals.
Yes, ozone’s effectiveness depends on factors like humidity, temperature, and exposure time. Additionally, it cannot penetrate solid materials, so surfaces must be clean and accessible for optimal results.